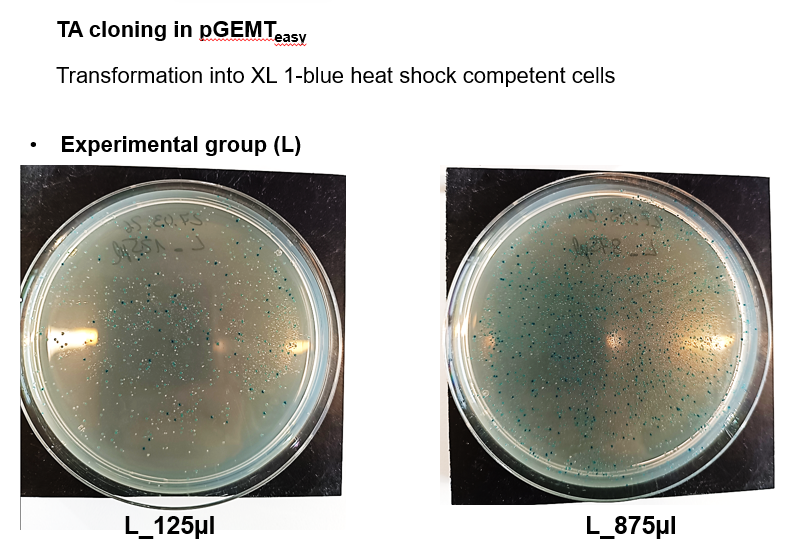
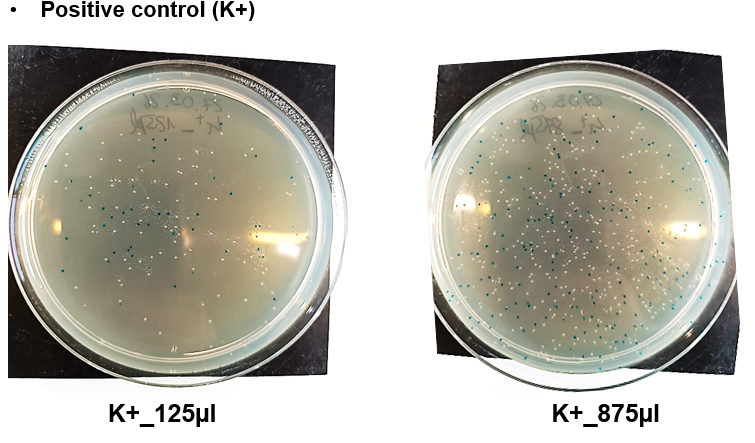
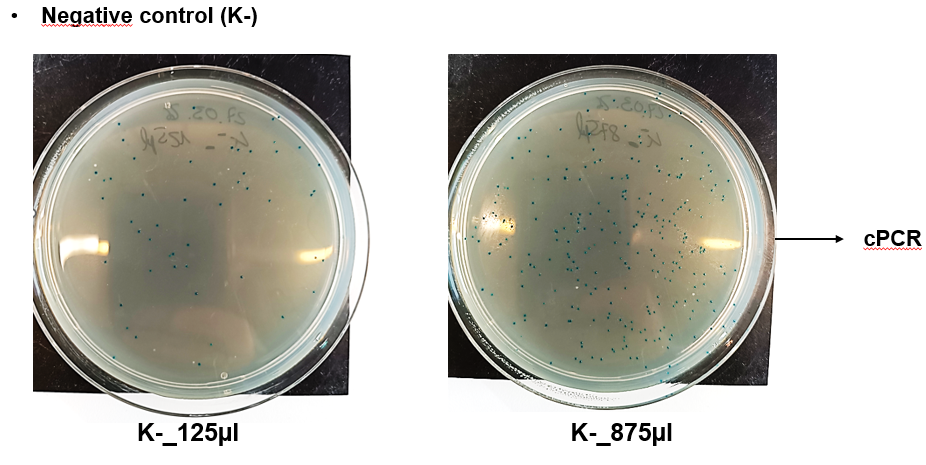

Summary molecular work
on Monday, March 30th, 2026 12:54 | by Julia Schulz





Category: Operant learning, PKC, TurboID-aPKC construct generation
on Monday, March 30th, 2026 12:54 | by Julia Schulz

Category: Operant learning, PKC, TurboID-aPKC construct generation
Leave a Reply